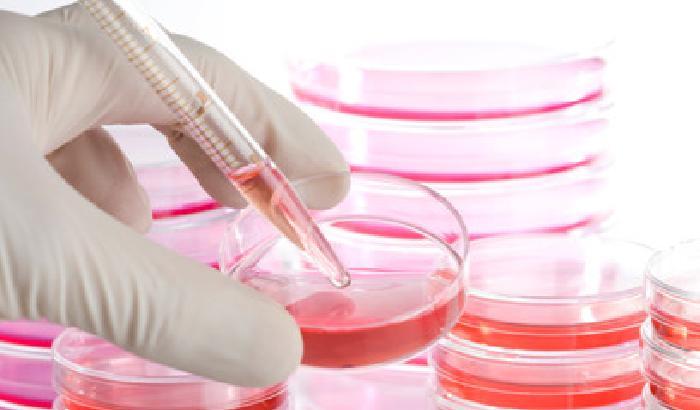
00CE7D-NEWS_104709 Stamina: tre esperti esclusi dal comitato ministeriale

Ancora cambiamenti per la commissione ministeriale incaricata di valutare l’efficacia del discusso protocollo Stamina. Secondo quanto rivelato da La Stampa, sono tre gli esperti che dovranno rinunciare all’incarico per la loro mancanza di imparzialità riguardo il contestato metodo ideato da Davide Vannoni. Un rischio che potrebbe portare la questione nuovamente davanti al Tar, dopo che lo stesso Tribunale aveva ordinato al ministero della Salute di annullare la prima commissione e costituirne una nuova. Un quarto è ancora sotto esame, ma anche lui rischierebbe la poltrona. Il decreto per la loro nomina non era ancora stato approvato ed era atteso proprio in questi giorni.
I tre scienziati sono Mauro Ferrari, scienziato italiano di fama internazionale ed esperto di nanotecnologie applicate alla medicina, Vania Broccoli, capo unità della Divisione di neuroscienze Stem Cell Research Institute all’Ospedale San Raffaele Milano, e Antonio Uccelli, clinico esperto in terapia cellulare del Centro per la sclerosi multipla dell’Università di Genova e responsabile della Neuroimmunologia al Centro di eccellenza per la ricerca biomedica (Cebr). I primi due sarebbero stati esclusi per motivi diversi da quelli del professor Ferrari, che sarebbe dovuto essere il presidente del comitato. Nel caso di quest’ultimo hanno pesato le sue opinioni, dchiarate anche in un’intervista alle Iene, in cui definiva Stamina come “il primo caso importante di medicina rigenerativa in Italia, un’occasione per il nostro Paese di assumere un ruolo di leadership straordinario”. Una posizione considerata a rischio ricorsi.
Nel caso degli altri due esperti, invece, hanno pesato le loro posizioni critiche nei confronti del protocollo.
[GotoHome_Torna alla Home]